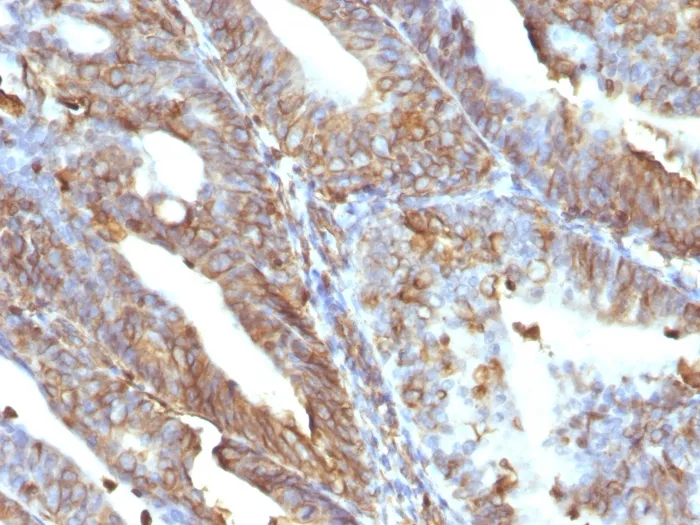
Anti-Vimentin (Mesenchymal Cell Marker)(V9) - image 1

Anti-Vimentin (Mesenchymal Cell Marker)(V9)
CAT:
37-BNUB2775-500
Size:
500 µL
Price:
Ask
- Availability: 24/48H Stock Items & 2 to 6 Weeks non Stock Items.
- Dry Ice Shipment: No

Anti-Vimentin (Mesenchymal Cell Marker)(V9)
Description:
This MAb reacts with a 58 kDa protein identified as vimentin. It shows no cross-reaction with other closely related intermediate filament proteins (IFP's) such as desmin, keratin, neurofilament, and glial fibrillary acid protein. Anti-vimentin alone is of limited value as a diagnostic tool; however, when used in panels with other antibodies, it is useful for the sub-classification of a given tumor. Expression of vimentin, when used in conjunction with anti-keratin, is helpful when distinguishing melanomas from undifferentiated carcinomas and large cell lymphomas. All melanomas and Schwannomas react strongly with anti-vimentin. It labels a variety of mesenchymal cells, including melanocytes, lymphocytes, endothelial cells, and fibroblasts. Non-reactivity of anti-vimentin is often considered more useful than its positive reactivity, since there are a few tumors that do not contain vimentin, e. g. hepatoma and seminoma. Anti-vimentin is also useful as a tissue process control reagent. Primary antibodies are available purified, or with a selection of fluorescent CF® Dyes and other labels. CF® Dyes offer exceptional brightness and photostability. Note: Conjugates of blue fluorescent dyes like CF®405S and CF®405M are not recommended for detecting low abundance targets, because blue dyes have lower fluorescence and can give higher non-specific background than other dye colors.Synonyms:
VIMUNSPSC:
41116161UNSPSC Description:
Primary and secondary antibodies for multiple methodology immunostaining detection applicationGene Name:
VIMGene ID:
7431NCBI Gene ID:
455493UniProt:
P08670Cellular Locus:
CytoskeletonHost:
MouseSpecies Reactivity:
HumanImmunogen:
Porcine LensTarget Antigen:
VimentinClonality:
MonoclonalIsotype:
IgG1 κClone:
V9Conjugation:
Purified, with BSASource:
AnimalApplications:
IHC, FFPE (verified) | WB (verified)Validated Applications:
IHC, FFPE, WBPositive Control:
U-87, Raji, Jurkat or HeLa cells. Sarcomas or Melanomas.Concentration:
0.2 mg/mLBuffer:
PBS, 0.05% BSA, 0.05% azideMolecular Weight:
57-60 kDaShipping Conditions:
Room temperatureStorage Conditions:
4°C; Stable at room temperature or 37°C (98°F) for 7 days.Shelf Life:
2 yearsCAS Number:
9007-83-4
DATASHEET Document
View DocumentMSDS Document
View Document